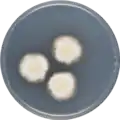

Aspergillus desertorum
Aspergillus desertorum is a species of fungus in the genus Aspergillus which has been isolated from desert soil.[4][5][3][1] It is from the Nidulantes section.[6] Aspergillus desertorum produces desertorin A, desertorin B, desertorin C, paxiline and emindol DA.[7][8][9][10]
| Aspergillus desertorum | |
|---|---|
| Scientific classification | |
| Kingdom: | Fungi |
| Division: | Ascomycota |
| Class: | Eurotiomycetes |
| Order: | Eurotiales |
| Family: | Trichocomaceae |
| Genus: | Aspergillus |
| Species: | A. desertorum |
| Binomial name | |
| Aspergillus desertorum (Samson & Mouchacca) Samson, Visagie & Houbraken (1974) Samson, Visagie & Houbraken (2014)[1] | |
| Type strain | |
| CBS 653.73, IFO 30840, IMI 343076, NBRC 30840, NRRL 5921[2] | |
| Synonyms | |
|
Emericella desertorum[3] | |
In 2016, the genome of A. desertorum was sequenced as a part of the Aspergillus whole-genome sequencing project - a project dedicated to performing whole-genome sequencing of all members of the genus Aspergillus.[11] The genome assembly size was 29.04 Mbp.[11]
Growth and morphology
A. desertorum has been cultivated on both Czapek yeast extract agar (CYA) plates and Malt Extract Agar Oxoid® (MEAOX) plates. The growth morphology of the colonies can be seen in the pictures below.
Aspergillus desertorum growing on CYA plate
Aspergillus desertorum growing on CYA plate Aspergillus desertorum growing on MEAOX plate
Aspergillus desertorum growing on MEAOX plate
References
- "Aspergillus desertorum". www.mycobank.org.
- "Emericella desertorum Taxon Passport - StrainInfo". www.straininfo.net.
- "Aspergillus desertorum". www.uniprot.org.
- Samson, R. A.; Mouchacca, J. (1974). "Some interesting species of Emericella and Aspergillus from Egyptian desert soil". Antonie van Leeuwenhoek. 40 (1): 121–131. doi:10.1007/BF00394559. PMID 4545193.
- "Emericella%20desertorum - Global Catalogue of Microorganisms". GCM.WFCC.info.
- Chen, A.J.; Frisvad, J.C.; Sun, B.D.; Varga, S.; Kocsubé, S.; Dijksterhuis, J.; Kim, D.H.; Hong, S.-B.; Houbraken, J.; Samson, R.A. (2016). "Aspergillus section Nidulantes (formerly Emericella): Polyphasic taxonomy, chemistry and biology". Studies in Mycology. 84: 1–118. doi:10.1016/j.simyco.2016.10.001. PMC 5198626. PMID 28050053.
- R.D.H. Murray, Progress in the Chemistry of Organic Natural Products; J.A. Robinson (1991). Tamm, Ch.; W. Herz; G.W. Kirby; W. Steglich (eds.). Fortschritte der Chemie organischer Naturstoffe. Vienna: Springer Vienna. ISBN 978-3-709-19141-5.
- Betina, Vladimír, ed. (1993). Chromatography of mycotoxins techniques and applications. Amsterdam: Elsevier. ISBN 978-0-080-85862-3.
- Wink, Michael, ed. (1999). Functions of plant secondary metabolites and their exploitation in biotechnology (1st ed.). Sheffield: Sheffield Acad. Press. ISBN 978-1-841-27008-1.
- Buckingham, J.; I.W. Southon; et al., eds. (1989). Dictionary of alkaloids (1st ed.). London: Chapman and Hall. ISBN 978-0-412-24910-5.
- "Home - Aspergillus desertorum CBS 653.73 v1.0".
Further reading
- Cordell, Geoffrey A., ed. (2003). The alkaloids. Amsterdam: Elservier Academic Press. ISBN 978-0-080-52149-7.
- R.H. Thomson, ed. (1993). The Chemistry of natural products (Second ed.). Dordrecht: Springer Netherlands. ISBN 978-9-401-12144-6.
- Martin, Robert (2011). Aromatic Hydroxyketones: Preparation and Physical Properties (3rd ed.). Dordrecht: Springer Science+Business Media B.V. ISBN 978-1-402-09787-4.
- Marco A., van den Berg; Karunakaran, Maruthachalam (2014). Genetic Transformation Systems in Fungi, Band 2. Springer. ISBN 978-3-319-10503-1.
- Krishnaswamy, N.R. (1999). Chemistry of natural products : a unified approach. Hyderabad, India: Universities Press. ISBN 978-8-173-71093-3.
- Rizzacasa, Mark A.; Sargent, Melvyn V. (1 January 1988). "The synthesis of desertorin C, a bicoumarin from the fungus Emericella desertorum". Journal of the Chemical Society, Perkin Transactions 1 (8): 2425–2428. doi:10.1039/P19880002425. ISSN 1364-5463.
- Samson, R. A.; Mouchacca, J. (1974). "Some interesting species of Emericella and Aspergillus from Egyptian desert soil". Antonie van Leeuwenhoek. 40 (1): 121–131. doi:10.1007/BF00394559. PMID 4545193.